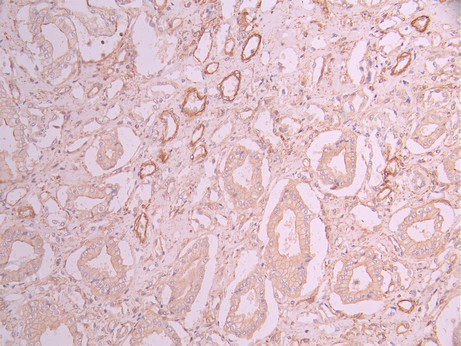

ACTA2 Recombinant Monoclonal Antibody
-
中文名稱:ACTA2 Recombinant Monoclonal Antibody
-
貨號:CSB-RA163563A0HU
-
規格:¥1320
-
圖片:
-
Western Blot
Positive WB detected in: Hela whole cell lysate(30μg), HT-29 whole cell lysate(30μg), COLO-205 whole cell lysate(30μg), HEK293 whole cell lysate(30μg), A431 whole cell lysate(30μg), A375 whole cell lysate(30μg), Mouse duodenum tissue lysate(30μg)
All lanes:alpha Smooth muscle actin antibody at 1:1000
Secondary
Goat polyclonal to rabbit IgG at 1/40000 dilution
Predicted band size: 42 kDa
Observed band size: 45 kDa
Exposure time:20s -
IHC image of CSB-RA163563A0HU diluted at 1:100 and staining in paraffin-embedded human glioma cancer performed on a Leica BondTM system. After dewaxing and hydration, antigen retrieval was mediated by high pressure in a citrate buffer (pH 6.0). Section was blocked with 10% normal goat serum 30min at RT. Then primary antibody (1% BSA) was incubated at 4°C overnight. The primary is detected by a Goat anti-rabbit polymer IgG labeled by HRP and visualized using 0.05% DAB.
-
IHC image of CSB-RA163563A0HU diluted at 1:100 and staining in paraffin-embedded human kidney tissue performed on a Leica BondTM system. After dewaxing and hydration, antigen retrieval was mediated by high pressure in a citrate buffer (pH 6.0). Section was blocked with 10% normal goat serum 30min at RT. Then primary antibody (1% BSA) was incubated at 4°C overnight. The primary is detected by a Goat anti-rabbit polymer IgG labeled by HRP and visualized using 0.05% DAB.
-
Immunofluorescence staining of HepG2 cell with CSB-RA163563A0HU at 1:50, counter-stained with DAPI. The cells were fixed in 4% formaldehyde, permeabilized using 0.2% Triton X-100 and blocked in 10% normal Goat Serum. The cells were then incubated with the antibody overnight at 4°C. The secondary antibody was Alexa Fluor 488-congugated AffiniPure Goat Anti-Rabbit IgG(H+L).
-
Overlay Peak curve showing HepG2 cells stained with CSB-RA163563A0HU (red line) at 1:100. The cells were fixed in 4% formaldehyde and permeated by 0.2% TritonX-100 for 10min. Then 10% normal goat serum to block non-specific protein-protein interactions followed by the antibody (1ug/1*106cells) for 45min at 4℃. The secondary antibody used was FITC-conjugated goat anti-rabbit IgG (H+L) at 1/200 dilution for 35min at 4℃.Control antibody (green line) was Rabbit IgG (1ug/1*106cells) used under the same conditions. Acquisition of >10,000 events was performed.
-
-
其他:
產品詳情
-
Uniprot No.:
-
基因名:
-
別名:Actin, aortic smooth muscle (Alpha-actin-2) (Cell growth-inhibiting gene 46 protein) [Cleaved into: Actin, aortic smooth muscle, intermediate form], ACTA2, ACTSA ACTVS
-
反應種屬:Human, Mouse
-
免疫原:A synthesized peptide from human ACTA2 protein
-
免疫原種屬:Homo sapiens (Human)
-
標記方式:Non-conjugated
-
克隆類型:Monoclonal
-
抗體亞型:Rabbit IgG
-
純化方式:Affinity-chromatography
-
克隆號:6E11
-
濃度:It differs from different batches. Please contact us to confirm it.
-
保存緩沖液:Preservative: 0.03% Proclin 300
Constituents: 50% Glycerol, 0.01M PBS, PH 7.4 -
產品提供形式:Liquid
-
應用范圍:ELISA, WB, IHC, IF, FC
-
推薦稀釋比:
Application Recommended Dilution WB 1:500-1:2000 IHC 1:50-1:200 IF 1:50-1:200 FC 1:50-1:200 -
Protocols:
-
儲存條件:Upon receipt, store at -20°C or -80°C. Avoid repeated freeze.
-
貨期:Basically, we can dispatch the products out in 1-3 working days after receiving your orders. Delivery time maybe differs from different purchasing way or location, please kindly consult your local distributors for specific delivery time.
-
用途:For Research Use Only. Not for use in diagnostic or therapeutic procedures.
相關產品
靶點詳情
-
功能:Actins are highly conserved proteins that are involved in various types of cell motility and are ubiquitously expressed in all eukaryotic cells.
-
基因功能參考文獻:
- Adenocarcinomas showed significantly higher staining scores of both VEGF and alphaSMA than squamous cell carcinomas did. In 42 cases of high CD31 score, five-year survival rate (87%) of patients with lung cancer showing mature tumor vessels was significantly better than that (69%) of patients with immature tumor vessels PMID: 29970531
- connective tissue disease including ACTA2 mutations should be considered for aortic dissection in young adult patients. PMID: 28808903
- cellular defects due to the ACTA2 mutation in both aortic smooth muscle cells and adventitial fibroblasts may contribute to development of thoracic aortic aneurysms and dissections and proliferative occlusive vascular disease PMID: 28652363
- our results seemed to justify the conclusion that ACTA2 did not play a significant role in the pathogenesis of BAV aortopathy. PMID: 29049801
- In patients with MYH11 or ACTA2 variants, the effect of intronic variants on splicing was demonstrated on the mRNA level in the induced smooth muscle cell (SMC), allowing classification into pathogenic or nonpathogenic variants. PMID: 28074631
- We present a young woman whose ACTA2 mutation was ascertained during pregnancy because of her father's history of dissecting aneurysms. She was delivered at full term by cesarean section and subsequently had severe uterine hemorrhage due to uterine atony. Targeted analysis of the patient's ACTA2 gene revealed she had inherited the N117S variant from her father. PMID: 29202781
- During transition from the pluripotent stage towards the neural developmental stage, ACTA2 is differentially expressed in bipolar patient derived cells compared to control derived cells. PMID: 28117838
- Two unrelated patients with the heterozygous R189H mutation in ACTA2 and complex congenital heart defects expands the cardiac phenotype of multisystemic smooth muscle dysfunction syndrome. PMID: 28328125
- Cells in high glucose for 7 days showed a significant decrease in mRNA expression of CD31 and VE-cadherin, and a significant increase in that of alpha-SMA and collagen I. PMID: 28347704
- ACTA2 is the isoform of contractile protein alpha-actin present in vascular smooth muscle cells (SMCs) throughout the arterial tree.4 Pathologic conditions in individuals with ACTA2 mutations show increased deposition of SMCs in the intimal arterial layer, leading to a decreased intraluminal diameter.4 PMID: 28343608
- Two novel actin alpha 2 mutations (N117I and L348R) were identified in each familial non-syndromatic thoracic aortic aneurysm proband separately, and an additional novel actin alpha 2 mutation (Y168N) was identified in one patient with sporadic non-syndromatic thoracic aortic aneurysm. PMID: 27431987
- The R179H mutation has the potential to affect actin structure and function in both the contractile domain of the cell and the more dynamic cytoskeletal pool of actin, both of which are required for contraction. PMID: 27551047
- site-directed mutagenesis revealed several basic amino acid residues in the intermolecular (R267) and intramolecular (K82 and R159) subdomains that are essential for Purbeta transcriptional repressor function in Acta2 promoter-reporter assays. In keeping with their diminished Acta2 repressor activity in fibroblasts, purified Purbeta variants containing an R267A mutation exhibited reduced binding affinity for purine-ric... PMID: 27064749
- Data show that the expression profiles of three proteins: E-cadherin, Snail, and alpha-smooth muscle actin were significantly different in extraprostatic extension prostate cancer (PCa) compared with intra-prostatic tumour. PMID: 26701730
- ACTA2 mutations are associated with structural disruption and functional impairment of contractile proteins, and predispose to a variety of diffuse vascular diseases including TAAD, CAD, ischemic strokes, and Moyamoya disease. Vascular SMCs are also implicated in vascular remodeling in both physiological and pathological conditions. PMID: 26934405
- Parenchymal alphaSMA expression in hepatic tissue appeared to increase only among hepatitis C subjects with fibrosis 3-4. PMID: 26927700
- Multisystemic smooth muscle dysfunction syndrome secondary to an ACTA2 mutation. PMID: 26835993
- alpha-SMA expression, and MLC phosphorylation, whereas butaprost inhibited TGF-beta2-induced CPCG contraction, actin polymerization, and MLC phosphorylation. PMID: 27082296
- Genetic analysis revealed a missense mutation of the ACTA2 gene, encoding for a smooth muscle isoform of alpha-actin. PMID: 27012699
- NGF has a role in modulating trkANGFR/p75NTR in alphaSMA-expressing conjunctival fibroblasts from human ocular cicatricial pemphigoid PMID: 26569118
- increased level of alphaSMA, a hallmark of epithelial mesenchymal transition in lens epithelial cells, is associated with increased level of histone H4 acetylation at the promoter region of alphaSMA gene(ACTA2) PMID: 25853442
- Mutations disrupting p.R179 and p.R258 were associated with significantly increased risk for aortic events, whereas p.R185Q and p.R118Q mutations showed significantly lower risk of aortic events compared with other mutations PMID: 25759435
- Alpha-SMA overexpression induced YAP translocation to the nucleus and reduced the high clonogenicity and adipogenic potential of alpha-SMA-negative MSCs. PMID: 26028530
- The number and distribution of myofibroblasts and the expression levels of ACTA2 in the fetal membrane may be involved in the mechanisms of development, apoptosis and trophoblastmyofibroblast transformation of the fetal membrane. PMID: 25954927
- All the variants analyzed expressed alpha-SMA mildly or moderately, except for the follicular variant that either did not express alpha-SMA or expressed it mildly. PMID: 26470744
- alphaSMA was not expressed in benign papillary hyperplastic lesions while it was expressed in papillary carcinoma PMID: 25921136
- Transforming growth factor-beta1 induces an up-regulation of alpha-SMA stress fibers in retinal Muller cells and fibroblasts and appears to have a cell-specific effect on intracellular collagen expression. PMID: 26447986
- Ca2+- and KCa3.1-dependent processes facilitate "constitutive" alpha smooth muscle actin expression and Smad2/3 signalling in IPF-derived fibroblasts, and thus promote fibroblast to myofibroblast differentiation. PMID: 25476248
- The effect of the R258C mutation in SM alpha-actin, is reported. PMID: 26153420
- ACTA2, FSP1, and PDGFRa are unfavorable prognostic indicators of esophageal squamous cell carcinoma patients. PMID: 24945657
- The immunohistochemical expression of E-cadherin and alpha-smooth muscle actin (alpha-SMA) in 15 cases of pleomorphic adenoma of salivary glands, were investigated. PMID: 25611270
- Epithelial-mesenchymal transition-related proteins CK-7 and alpha-SMA colocalized to the intrahepatic biliary epithelial cells in patients with biliary atresia. PMID: 25406900
- The ACTA2 gene encodes the smooth muscle alpha2-actin protein. Pathogenic mutations within ACTA2 result in disrupted contractility and are a recognized cause of aortic dissection PMID: 26034244
- We report a missense mutation in the smooth muscle alpha-actin (ACTA2; MIM*102620) gene in a 3 generational family from Northern Ireland in which iris flocculi were an ocular marker of the disease. PMID: 24020716
- We report a case of ACTA2 mutation in a 3-year-old girl presenting with acute ischemic stroke PMID: 24353327
- Women with ACTA2 mutations who are planning to get pregnant should be counseled about this risk of aortic dissection, and proper clinical management should be initiated to reduce this risk. PMID: 24243736
- alpha-SMA could be a useful marker for the detection of early stage fibrosis in liver transplant recipients stopping immunosuppressive therapy. PMID: 24966580
- This study analyzes the microvascular density (MVD) for CD105+ and alpha-SMA+ vessels and VEGF immunoexpression for 35 oral squamous cell carcinomas and for the associated dysplastic lesions of the lips. PMID: 24715163
- This case illustrates the spectrum of systemic malformations that are attributable to mutations in ACTA2 and expands the spectrum of cerebrovascular anomalies that are now known to accompany congenital mydriasis. PMID: 24998021
- Identical twin brothers were identified with severe progressive thoracic aortic aneurysm due to ACTA2 mutation. PMID: 25225139
- Relationships of alpha-SMA-positive fibroblasts and SDF-1-positive tumor cells with neoangiogenesis in nasopharyngeal carcinoma. PMID: 24877105
- High ACTA2 expression is associated with pancreatic cancer. PMID: 25314063
- genetic testing revealed new mutations in FBN1, TGFbetaR1, TGFbetaR2 and ACTA2 detected in patients with clinical diagnosis of Marfan Syndrome, Loeys-Dietz Syndrome and Thoracic Aortic Aneurysms and Dissections. PMID: 24793577
- Significant down-regulation of the ACTA2 gene, encoding the cytoskeletal protein alpha 2 actin, in response to RHOA knockdown in both osteoblast-like and osteoclast-like cells. PMID: 24840563
- Sphingosylphosphorylcholine stimulates alpha-SMA protein expression and human lung fibroblast mediated collagen gel contraction via S1P2 receptor. PMID: 24614064
- Suggest dynamic interplay between transcriptional activators Pur-alpha/Pur-beta and repressors in regulating SMalphaA gene output during myofibroblast differentiation. PMID: 24446247
- Angiogenesis evaluated through the VEGF and MVD (CD105+ and alpha-SMA+) expression is correlated with the progression and metastasis of gastric cancer and could be considered a prognostic marker of these tumors. PMID: 24322015
- ACTA2 regulates c-MET and FAK expression in lung adenocarcinoma cells, which positively and selectively influence metastatic potential. PMID: 23995859
- findings confirmed that ACTA2 did not play an important role in the pathogenesis of moyamoya disease PMID: 24024919
- Our data suggest that ACTA2 is not a major disease-causing gene for spontaneous cerebral artery dissection PMID: 23879759
顯示更多
收起更多
-
相關疾病:Aortic aneurysm, familial thoracic 6 (AAT6); Moyamoya disease 5 (MYMY5); Multisystemic smooth muscle dysfunction syndrome (MSMDYS)
-
亞細胞定位:Cytoplasm, cytoskeleton.
-
蛋白家族:Actin family
-
數據庫鏈接:
Most popular with customers
-
-
YWHAB Recombinant Monoclonal Antibody
Applications: ELISA, WB, IHC, IF, FC
Species Reactivity: Human, Mouse, Rat
-
Phospho-YAP1 (S127) Recombinant Monoclonal Antibody
Applications: ELISA, WB, IHC
Species Reactivity: Human
-
-
-
-
-